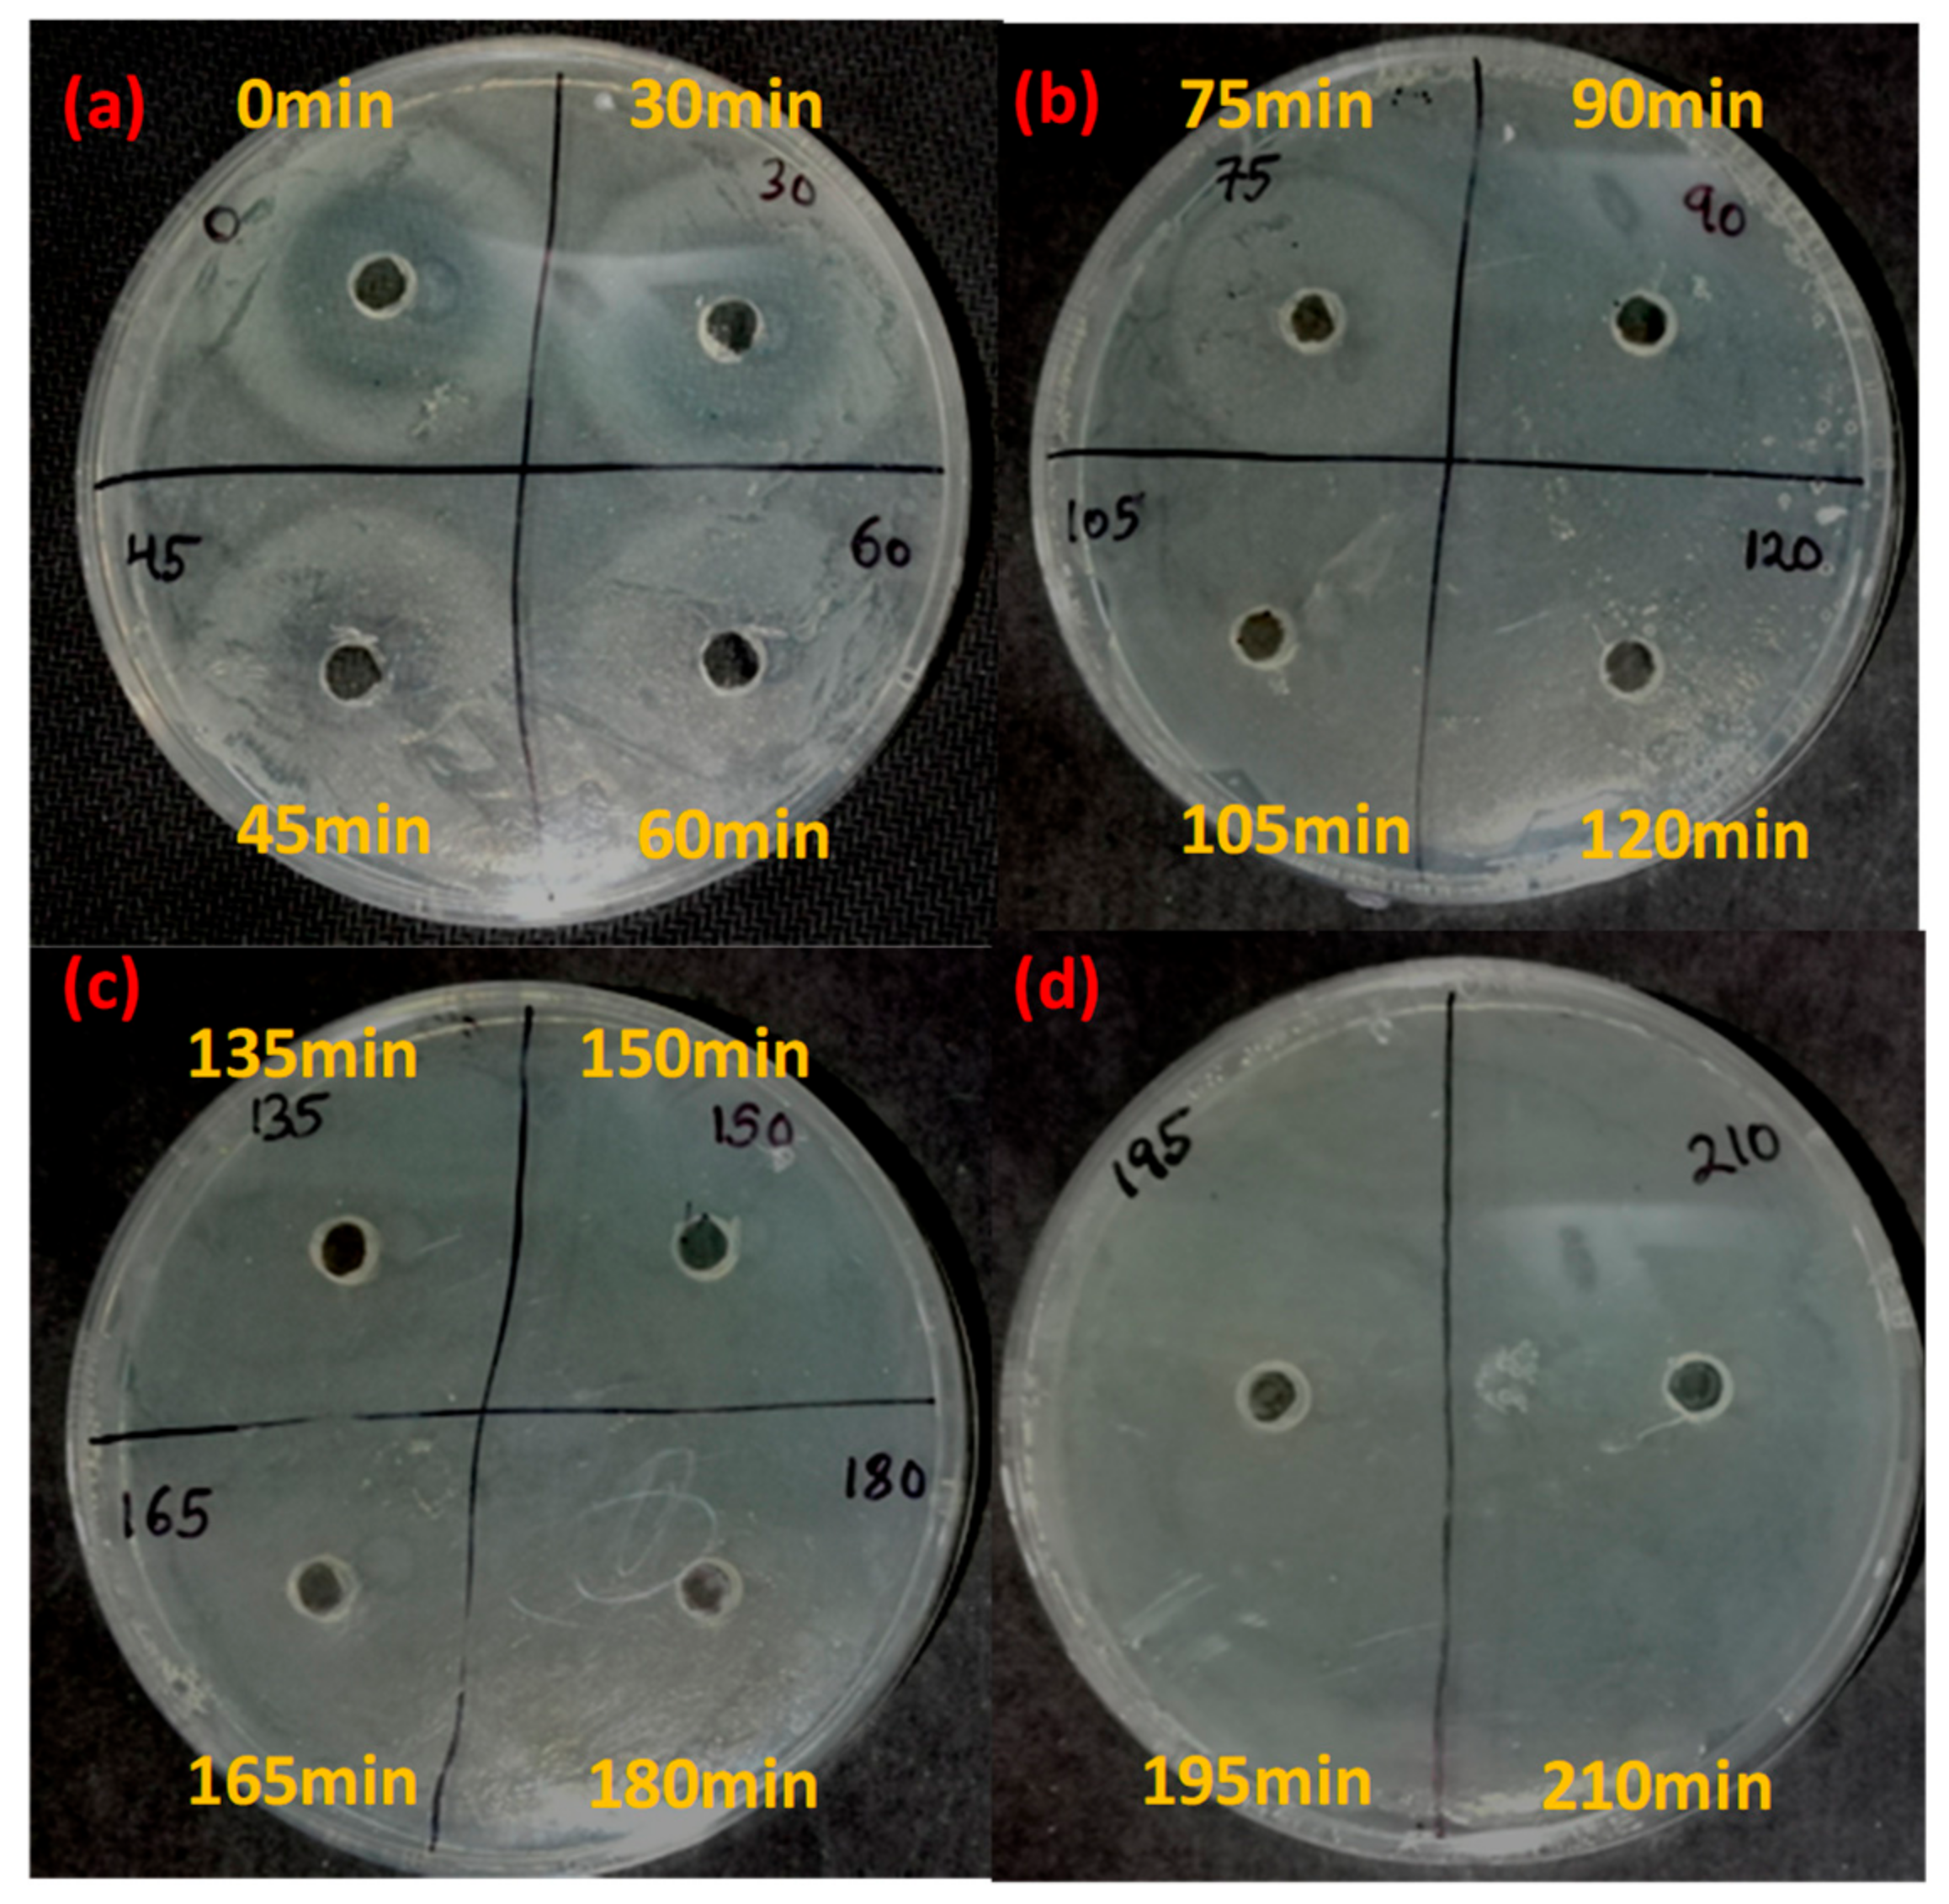
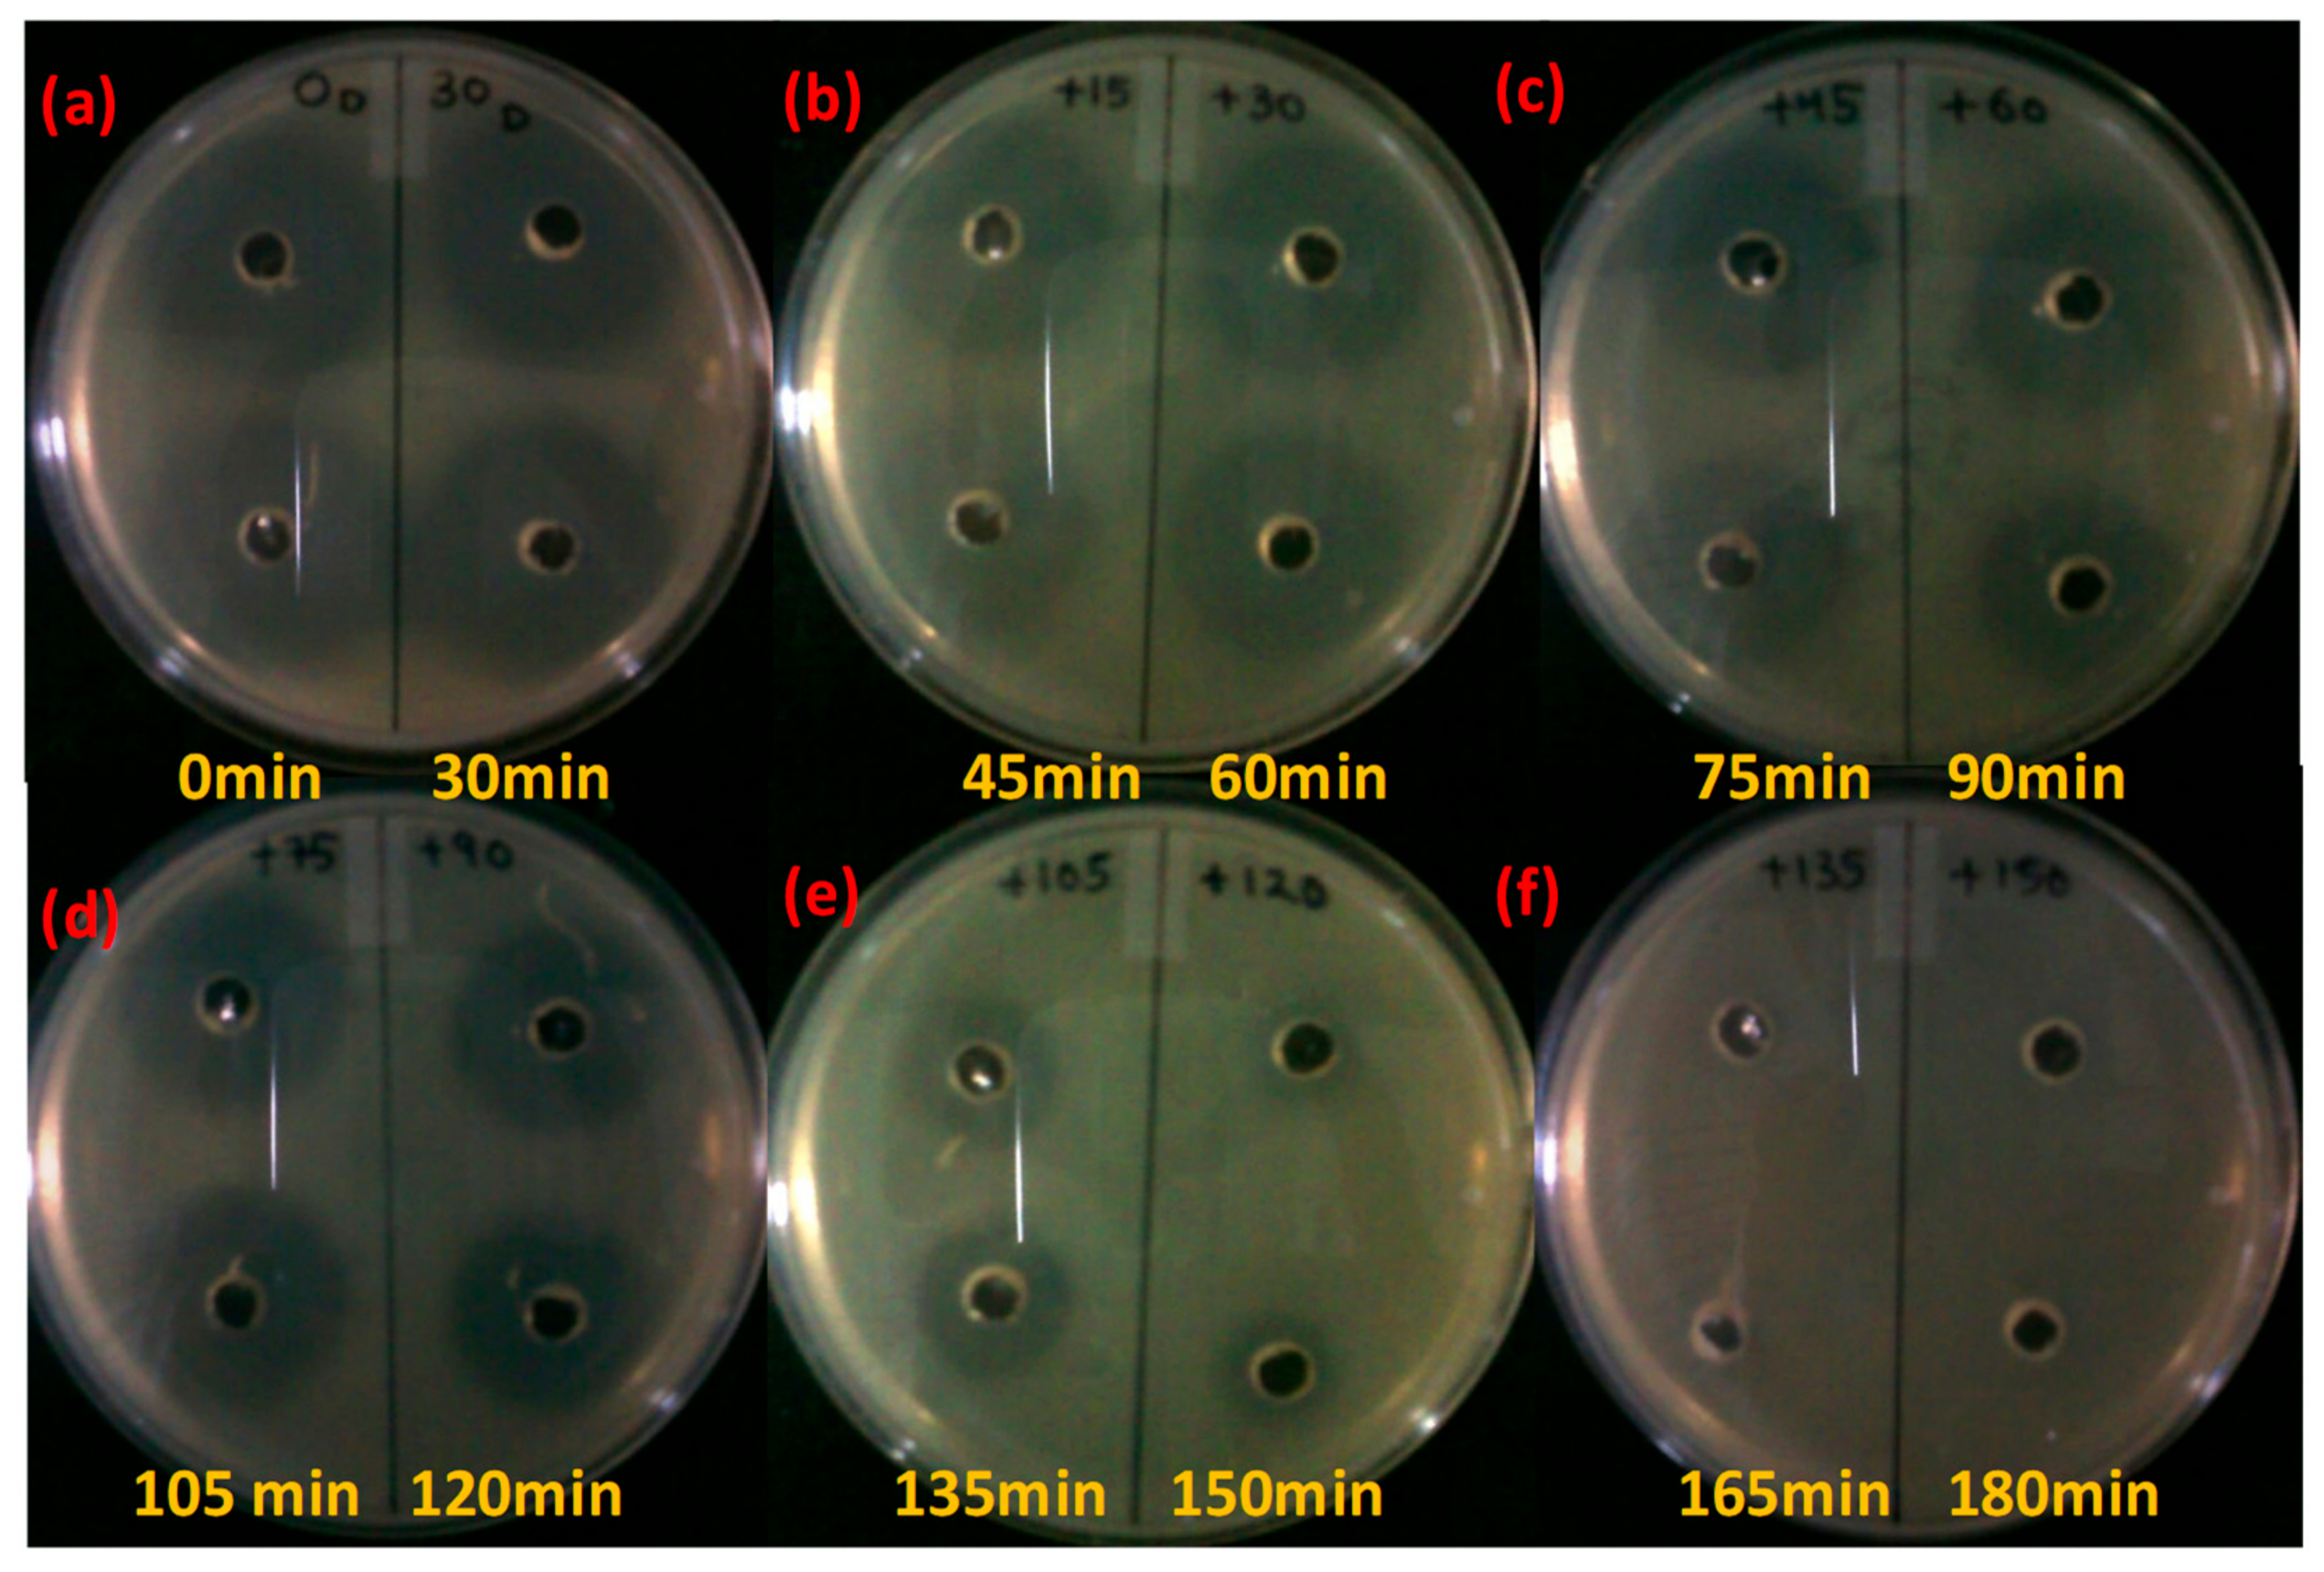

Sunlight Assisted Photocatalytic Degradation of Ciprofloxacin in Water Using Fe Doped ZnO Nanoparticles for Potential Public Health Applications
Abstract
1. Introduction
2. Materials and Methods
2.1. Materials
2.2. Preparation of Ciprofloxacin Stock Solution
2.3. Synthesis of Nanocrystalline Fe-Doped ZnO
2.4. Photocatalytic Degradation of Ciprofloxacin
2.5. Residual Antibacterial Activity of the Treated Water
3. Results and Discussion
3.1. Photocataltytic Degradation of Ciprofloxacin and Process Optimization
3.2. Analysis of Residual Antibacterial Activity of Antibiotic after Photocatalytic Degradation
4. Conclusions
Author Contributions
Funding
Conflicts of Interest
References
- Lundborg, C.S.; Tamhankar, A. Antibiotic residues in the environment of South East Asia. BMJ 2017, 358, j2440. [Google Scholar] [CrossRef] [PubMed]
- Walsh, C. Opinion—Anti-infectives: Where will new antibiotics come from? Nat. Rev. Microbiol. 2003, 1, 65–70. [Google Scholar] [CrossRef] [PubMed]
- Paul, T.; Dodd, M.C.; Strathmann, T.J. Photolytic and photocatalytic decomposition of aqueous ciprofloxacin: Transformation products and residual antibacterial activity. Water Res. 2010, 1, 3121–3132. [Google Scholar] [CrossRef] [PubMed]
- Yan, C.; Yang, Y.; Zhou, J.; Liu, M.; Nie, M.; Shi, H.; Gu, L. Antibiotics in the surface water of the Yangtze Estuary: Occurrence, distribution and risk assessment. Environ. Pollut. 2013, 175, 22–29. [Google Scholar] [CrossRef] [PubMed]
- Cantón, R.; Horcajada, J.P.; Oliver, A.; Garbajosa, P.R.; Vila, J. Inappropriate use of antibiotics in hospitals: the complex relationship between antibiotic use and antimicrobial resistance. Enferm. Infect. Microbiol. Clin. 2013, 31, 3–11. [Google Scholar] [CrossRef]
- Larsson, D.J.; de Pedro, C.; Paxeus, N. Effluent from drug manufactures contains extremely high levels of pharmaceuticals. J. Hazard. Mater. 2007, 148, 751–755. [Google Scholar] [CrossRef] [PubMed]
- Selvam, K.; Swaminathan, M. Facile Synthesis of 2-Methylquinolines From Anilines on Mesoporous N-Doped TiO2 Under UV and Visible Light. Synth. React. Inorg. Met.-Org. Nano-Met. Chem. 2013, 43, 500–508. [Google Scholar] [CrossRef]
- Sturini, M.A.; Maraschi, F.; Pretali, L.; Ferri, E.N.; Profumo, A. Sunlight-induced degradation of fluoroquinolones in wastewater effluent: Photoproducts identification and toxicity. Chemosphere 2015, 134, 313–318. [Google Scholar] [CrossRef] [PubMed]
- Rutgersson, C.; Fick, J.; Marathe, N.; Kristiansson, E.; Janzon, A.; Angelin, M.; Johansson, A.; Shouche, Y.; Flach, C.-F.; Larsson, D.J. Fluoroquinolones and qnr genes in sediment, water, soil, and human fecal flora in an environment polluted by manufacturing discharges. Environ. Sci. Technol. 2014, 48, 7825–7832. [Google Scholar] [CrossRef] [PubMed]
- Ikehata, K.; Naghashkar, N.J.; El-Din, M.G. Degradation of aqueous pharmaceuticals by ozonation and advanced oxidation processes: A review. Ozone-Sci. Eng. 2006, 28, 353–414. [Google Scholar] [CrossRef]
- Chong, M.N.; Jin, B.; Chow, C.W.; Saint, C. Recent developments in photocatalytic water treatment technology: A review. Water Res. 2010, 44, 2997–3027. [Google Scholar] [CrossRef] [PubMed]
- Saleh, R.; Djaja, N.F. UV light photocatalytic degradation of organic dyes with Fe-doped ZnO nanoparticles. Superlattices Microstruct. 2014, 74, 217–233. [Google Scholar] [CrossRef]
- Elmolla, E.S.; Chaudhuri, M. Degradation of amoxicillin, ampicillin and cloxacillin antibiotics in aqueous solution by the UV/ZnO photocatalytic process. J. Hazard. Mater. 2010, 173, 445–449. [Google Scholar] [CrossRef] [PubMed]
- El-Kemary, M.; El-Shamy, H.; El-Mehasseb, I. Photocatalytic degradation of ciprofloxacin drug in water using ZnO nanoparticles. J. Lumin. 2010, 130, 2327–2331. [Google Scholar] [CrossRef]
- Das, S.; Sinha, S.; Das, B.; Jayabalan, R.; Suar, M.; Mishra, A.; Tamhankar, A.J.; Lundborg, C.S.; Tripathy, S.K. Disinfection of multidrug resistant Escherichia coli by solar-photocatalysis using Fe-doped ZnO nanoparticles. Sci Rep. 2017, 7, 104. [Google Scholar] [CrossRef] [PubMed]
- Srivastava, V.C. Photocatalytic oxidation of dye bearing wastewater by iron doped zinc oxide. Ind. Eng. Chem. Res. 2013, 52, 17790–17799. [Google Scholar]
- Kerr, J. Antibiotic Treatment and Susceptibility Testing; BMJ Publishing Group: London, UK, 2005. [Google Scholar]
- Bonev, B.; Hooper, J.; Parisot, J. Principles of assessing bacterial susceptibility to antibiotics using the agar diffusion method. J. Antimicrob. Chemother. 2008, 61, 1295–1301. [Google Scholar] [CrossRef] [PubMed]
- Kusari, S.; Prabhakaran, D.; Lamshöft, M.; Spiteller, M. In vitro residual anti-bacterial activity of difloxacin, sarafloxacin and their photoproducts after photolysis in water. Environ. Pollut. 2009, 157, 2722–2730. [Google Scholar] [CrossRef] [PubMed]
- Achouri, F.; Corbel, S.; Aboulaich, A.; Balan, L.; Ghrabi, A.; Said, M.B.; Schneider, R. Aqueous synthesis and enhanced photocatalytic activity of ZnO/Fe2O3 heterostructures. J. Phys. Chem. Solids 2014, 75, 1081–1087. [Google Scholar] [CrossRef]
- Torniainen, K.; Tammilehto, S.; Ulvi, V. The effect of pH, buffer type and drug concentration on the photodegradation of ciprofloxacin. Int. J. Pharm. 1996, 132, 53–61. [Google Scholar] [CrossRef]
- Gupta, N.; Pandey, P.; Hussain, J. Effect of physicochemical and biological parameters on the quality of river water of Narmada, Madhya Pradesh, India. Water Sci. 2017, 31, 11–23. [Google Scholar] [CrossRef]
- Sturini, M.; Speltini, A.; Maraschi, F.; Pretali, L.; Profumo, A.; Fasani, E.; Albini, A.; Migliavacca, R.; Nucleo, E. Photodegradation of fluoroquinolones in surface water and antimicrobial activity of the photoproducts. Water Res. 2012, 46, 5575–5582. [Google Scholar] [CrossRef] [PubMed]
- Chatzitakis, A.; Berberidou, C.; Paspaltsis, I.; Kyriakou, G.; Sklaviadis, T.; Poulios, I. Photocatalytic degradation and drug activity reduction of chloramphenicol. Water Res. 2008, 42, 386–394. [Google Scholar] [CrossRef] [PubMed]
- Bousslama, W.; Elhouichet, H.; Férid, M. Enhanced photocatalytic activity of Fe doped ZnO nanocrystals under sunlight irradiation. Optik-Int. J. Light Electron Opt. 2017, 134, 88–98. [Google Scholar] [CrossRef]
- Roca, M.; Villegas, L.; Kortabitarte, M.; Althaus, R.; Molina, M. Effect of heat treatments on stability of β-lactams in milk. J. Dairy Sci. 2011, 94, 1155–1164. [Google Scholar] [CrossRef] [PubMed]
- Lamba, M.; Graham, D.W.; Ahammad, S.Z. Hospital wastewater releases of carbapenem-resistance pathogens and genes in urban India. Environ. Sci. Technol. 2017, 51, 13906–13912. [Google Scholar] [CrossRef] [PubMed]
- Sonohara, R.; Muramatsu, N.; Ohshima, H.; Kondo, T. Difference in surface properties between Escherichia coli and Staphylococcus aureus as revealed by electrophoretic mobility measurements. Biophys. Chem. 1995, 55, 273–277. [Google Scholar] [CrossRef]
- Li, J.; Ahn, J.; Liu, D.; Chen, S.; Ye, X.; Ding, T. Evaluation of ultrasound induced damage on Escherichia coli and Staphylococcus aureus by flow cytometry and transmission electron microscopy. Appl. Environ. Microbiol. 2016, 82, 1828–1837. [Google Scholar] [CrossRef] [PubMed]

| Test Bacteria | Staphylococcus Aureus (108 CFU) | Escherichia Coli (108 CFU) | ||||
|---|---|---|---|---|---|---|
| Time (min) | PCD ZOI in mm Mean ± SEM | DC ZOI in mm Mean ± SEM | PL ZOI in mm Mean ± SEM | PCD ZOI in mm Mean ± SEM | DC ZOI in mm Mean ± SEM | PL ZOI in mm Mean ± SEM |
| 0 | 12 ± 0.3 | 12.5 ± 0.3 | 12.5 ± 0.2 | 15 ± 0.3 | 15 ± 0.2 | 14.5 ± 0.3 |
| 30 | 12.5 ± 0.3 | 12 ± 0.3 | 12.5 ± 0.2 | 14.5 ± 0.3 | 14.5 ± 0.2 | 14.5 ± 0.2 |
| 45 | 10 ± 0.3 | 8 ± 0.5 | 11 ± 0.2 | 11 ± 0.3 | 14 ± 0.2 | 14 ± 0.2 |
| 60 | 7.5 ± 0.2 | 12 ± 0.5 | 10 ± 0.2 | 12 ± 0.4 | 14 ± 0.2 | 13.5 ± 0.3 |
| 75 | 5.5 ± 0.2 | 11 ± 0.3 | 10.5 ± 0.2 | 9.5 ± 0.3 | 14.5 ± 0.2 | 12 ± 0.5 |
| 90 | 0 | 11.5 ± 0.5 | 9 ± 0.3 | 6 ± 0.2 | 14.5 ± 0.2 | 11.5 ± 0.3 |
| 105 | 0 | 9 ± 0.3 | 8.5 ± 0.2 | 0 | 12 ± 0.3 | 12 ± 0.3 |
| 120 | 0 | 10 ± 0.2 | 7.5 ± 0.3 | 0 | 12.5 ± 0.4 | 10 ± 0.3 |
| 135 | 0 | 10 ± 0.3 | 8 ± 0.2 | 0 | 14 ± 0.3 | 9 ± 0.3 |
| 150 | 0 | 10.5 ± 0.2 | 7 ± 0.2 | 0 | 14 ± 0.2 | 8.5 ± 0.2 |
| 165 | 0 | 9 ± 0.3 | 6 ± 0.2 | 0 | 14.5 ± 0.3 | 7 ± 0.2 |
| 180 | 0 | 11 ± 0.3 | 5.5 ± 0.2 | 0 | 14 ± 0.2 | 0 |
| 195 | 0 | 11 ± 0.2 | 0 | 0 | 14 ± 0.3 | 0 |
| 210 | 0 | 12 ± 0.3 | 0 | 0 | 13 ± 0.5 | 0 |
© 2018 by the authors. Licensee MDPI, Basel, Switzerland. This article is an open access article distributed under the terms and conditions of the Creative Commons Attribution (CC BY) license (http://creativecommons.org/licenses/by/4.0/).
Share and Cite
Das, S.; Ghosh, S.; Misra, A.J.; Tamhankar, A.J.; Mishra, A.; Lundborg, C.S.; Tripathy, S.K. Sunlight Assisted Photocatalytic Degradation of Ciprofloxacin in Water Using Fe Doped ZnO Nanoparticles for Potential Public Health Applications. Int. J. Environ. Res. Public Health 2018, 15, 2440. https://doi.org/10.3390/ijerph15112440
Das S, Ghosh S, Misra AJ, Tamhankar AJ, Mishra A, Lundborg CS, Tripathy SK. Sunlight Assisted Photocatalytic Degradation of Ciprofloxacin in Water Using Fe Doped ZnO Nanoparticles for Potential Public Health Applications. International Journal of Environmental Research and Public Health. 2018; 15(11):2440. https://doi.org/10.3390/ijerph15112440
Chicago/Turabian StyleDas, Sourav, Soumen Ghosh, Ananyo Jyoti Misra, Ashok J. Tamhankar, Amrita Mishra, Cecilia Stålsby Lundborg, and Suraj K. Tripathy. 2018. "Sunlight Assisted Photocatalytic Degradation of Ciprofloxacin in Water Using Fe Doped ZnO Nanoparticles for Potential Public Health Applications" International Journal of Environmental Research and Public Health 15, no. 11: 2440. https://doi.org/10.3390/ijerph15112440
APA StyleDas, S., Ghosh, S., Misra, A. J., Tamhankar, A. J., Mishra, A., Lundborg, C. S., & Tripathy, S. K. (2018). Sunlight Assisted Photocatalytic Degradation of Ciprofloxacin in Water Using Fe Doped ZnO Nanoparticles for Potential Public Health Applications. International Journal of Environmental Research and Public Health, 15(11), 2440. https://doi.org/10.3390/ijerph15112440

